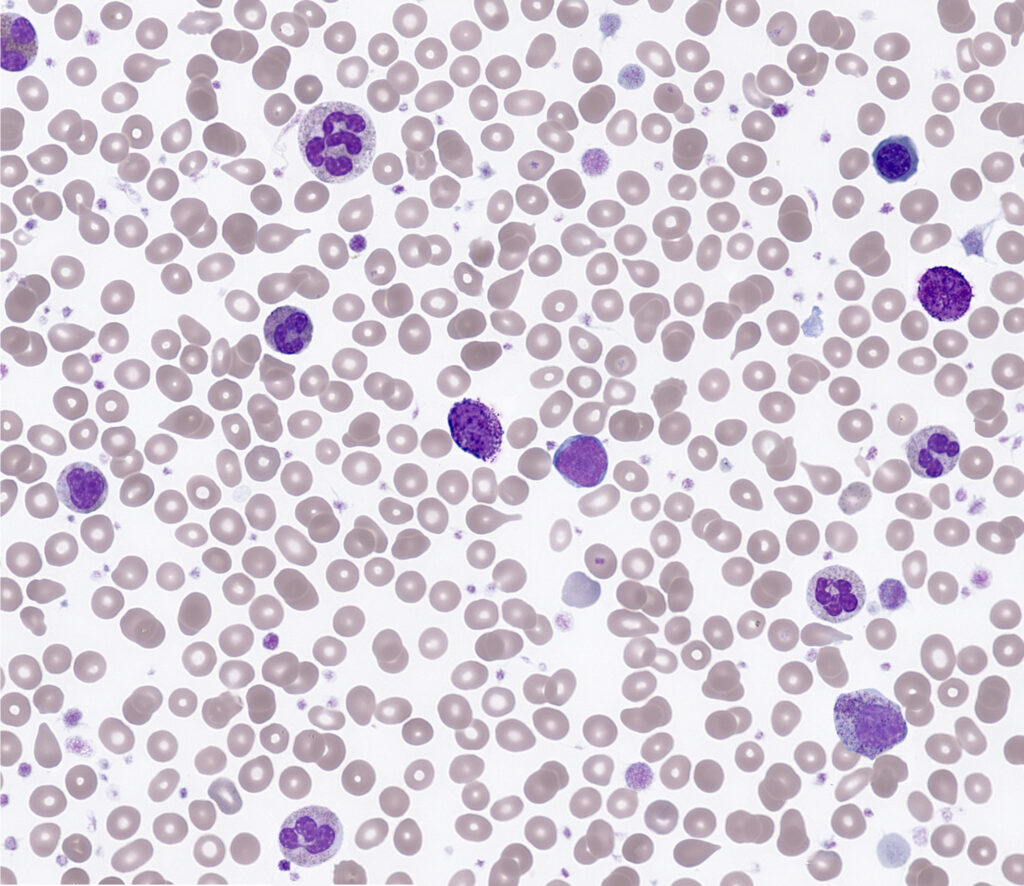
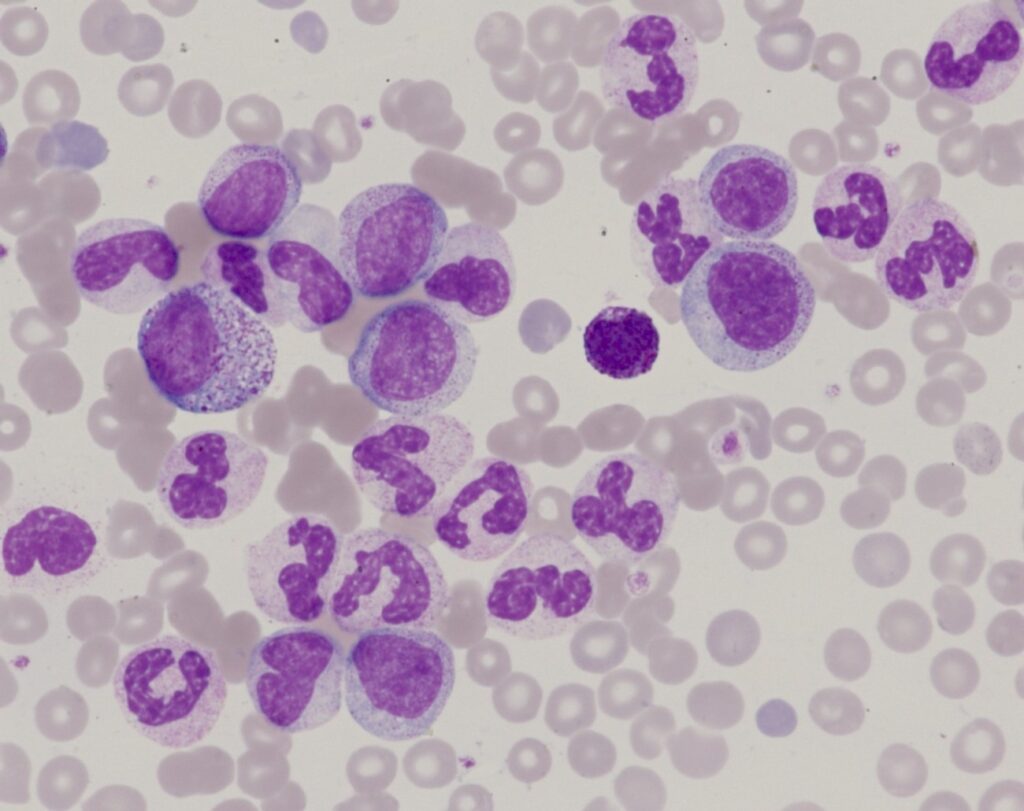
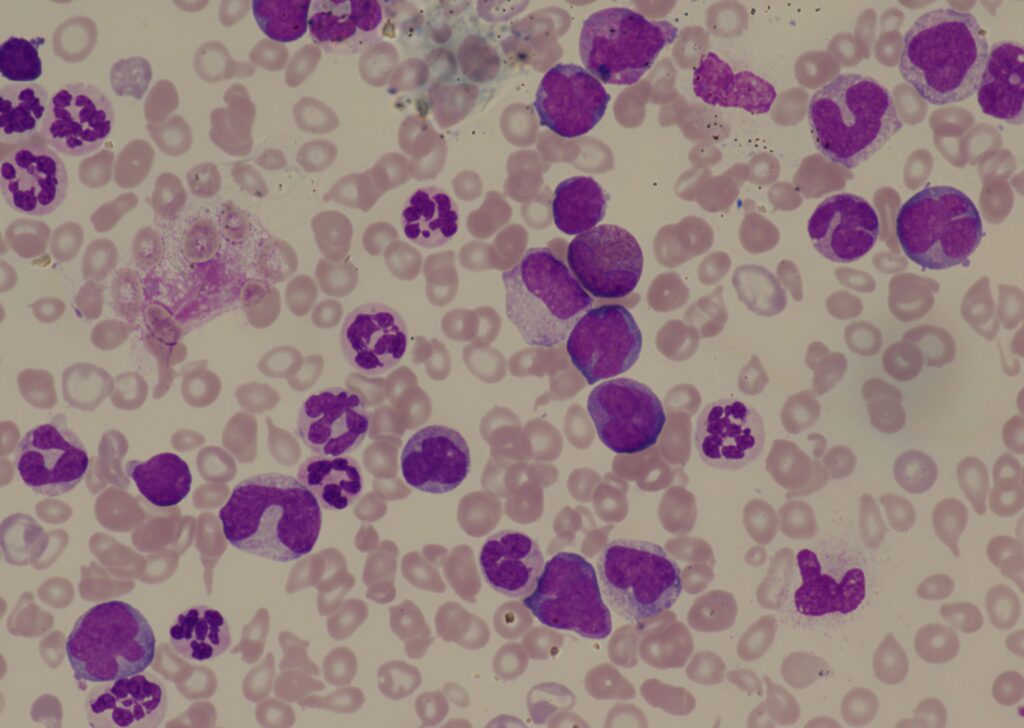

This site is intended for use for users of HCDP Greater Manchester.
It provides guidance as to how to:
- Navigate the diagnostic pathways
- Follow-up patients with diagnoses of acute leukaemia (MRD)
- Links to clinical diagnostic calculators
This guidance is for routine samples and is intended to be an overview. Specific guidance will be issued by the Genomics Laboratory depending on results.